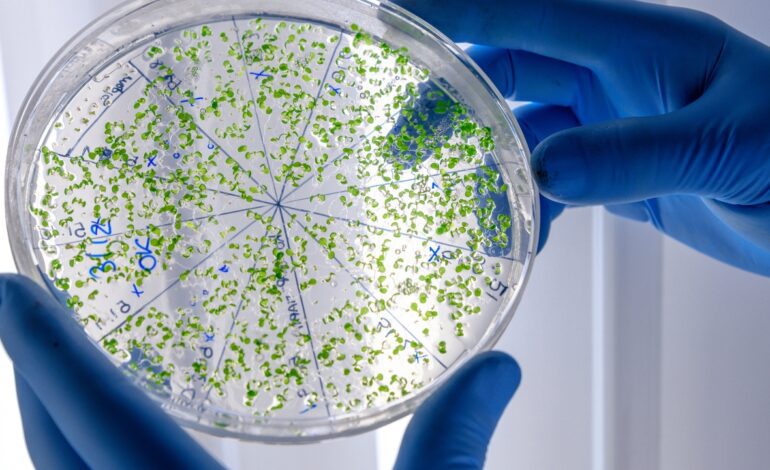
Descubren cómo los virus aprenden a burlar a bacterias resistentes y abren la puerta a nuevos tratamientos

Descubren cómo los virus aprenden a burlar a bacterias resistentes y abren la puerta a nuevos tratamientos
Un equipo del Instituto de Biología Integrativa de Sistemas ha identificado cómo determinados virus que infectan exclusivamente a bacterias, los famosos fagos, son capaces de modificar sus proteínas y compartir fragmentos de su genoma para cruzarse y atacar a determinadas bacterias peligrosas.
Cómo se adaptan los virus
La investigación, dirigida por Celia Ferriol-González y la profesora Pilar Domingo-Calap, se centró en comprender el mecanismo que permite que los fagos evolucionen para infectar bacterias del género Klebsiella. Estas bacterias, comunes en los hospitales, son responsables de infecciones graves y están en la lista de patógenos prioritarios de la OMS para su Alta resistencia a los antibióticos.
EL Klebsiella Está protegido por una cápsula externa que actúa como escudo contra drogas y virus. Según estudios previos del mismo grupo de investigación, la mayoría de los fagos sólo son capaces de atacar uno o muy pocos tipos de cápsulas, lo que limita su eficacia. Sin embargo, el nuevo trabajo revela que algunos fagos pueden crecer estructuras más flexibles que les permiten reconocer y atravesar diferentes tipos de cápsulas.
Estrategias escalables para aumentar tu capacidad de ataque
Los fagos utilizan proteínas de unión a receptores para reconocer la superficie bacteriana. En los fagos “especialistas”, estas proteínas son rígidas y están diseñadas para un solo tipo de cápsula. Pero en los fagos «generalistas», estas proteínas son mucho más flexibles, permitiéndoles infectar múltiples variantes de la bacteria Klebsiella.
Además, el estudio muestra que los fagos pueden intercambiar partes de su material genético, incluidas proteínas clave, un proceso que acelera su evolución y amplía su rango de ataque. «Seguir la evolución de múltiples fagos al mismo tiempo en una comunidad con tantas bacterias y tipos de cápsulas fue uno de los grandes desafíos del estudio», dice Ferriol-González.
Este descubrimiento representa un importante paso adelante para el futuro de Terapia con fagos, una alternativa a los antibióticos. está ganando terreno. Según Domingo-Calap, entender cómo se adaptan estos virus permitirá diseñar tratamientos personalizados y más precisos para cada tipo de infección. También abre la puerta al uso de la evolución dirigida para mejorar las proteínas virales y hacerlas más efectivas.
Síguenos en nuestro canal whatsapp y no te pierdas las últimas novedades y todas las novedades de nuestra perfil de google.
Puedes consultar la fuente de este artículo aquí




